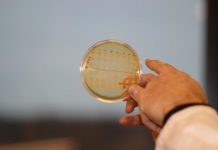
Research: Scientists to produce anti-cancer drugs in yeast —

Research: Industrial fisheries are starving seabirds all around the world —
Industrial fisheries are starving seabirds like penguins and terns by competing for the same prey sources, new research from the French National Center...
Research: Increasing seal population will not harm largest fish stocks in the Baltic —
Seals feeding on fish does not decrease fish stocks of Baltic cod, herring and sprat the most -- climate change, nutrient load and...
Research: Silicosis is on the rise, but is there a therapeutic target? —
Researchers from the CNRS, the University of Orléans, and the company Artimmune, in collaboration with Turkish clinicians from Atatürk University, have identified a...
Research: Simple steps to climate-proof farms have big potential upside for tropical farmers —
Cacao farmers in Nicaragua lose their crop, the main ingredient for chocolate, to fungal blight and degrading soils. Yields drop in Vietnam's rice...
Research: One out of three rivers in the Iberian Peninsula is affected by salinization...
These are some of the red lines revealed in the special volume on salinization in water ecosystems, published this December in the journal...
Research: How ice particles promote the formation of radicals —
The production of chlorofluorocarbons, which damage the ozone layer, has been banned as far as possible. However, other substances can also tear holes...
Research: Scientists to produce anti-cancer drugs in yeast —
Nature is so complex that natural molecules used for i.e. cancer treatment still can't be produced by chemical synthesis. Today, major chemical and...
Research: Wintertime arctic sea ice growth slows long-term decline —
New NASA research has found that increases in the rate at which Arctic sea ice grows in the winter may have partially slowed...
Research: News about a plant hormone —
Jasmonic acid is not just the aromatic odor of the plant Jasminum grandiflorum used in cosmetics and perfume industries. Plants wounded by e.g....
Research: Potential implications of transitioning to plant-based plastics —
Bioplastics are often promoted as an environmentally and climate-friendly alternative to conventional petroleum-based plastics. However, a recent study from the University of Bonn...
Top News
Hey ISIS, You Suck: Local Muslims Post Anti-ISIS Billboard
A new billboard on Manchester Road in Missouri reads, "HEY ISIS, YOU SUCK!!! From: #ActualMuslims."
A group of Muslim-Americans have put up a blunt billboard...